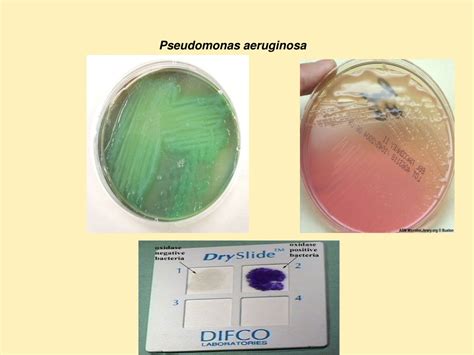

Pseudomonas Aeruginosa SC2014SC: A Comprehensive Guide
Pseudomonas aeruginosa SC2014SC: A Comprehensive Guide
Hey everyone! Today, we’re diving deep into the fascinating world of Pseudomonas aeruginosa SC2014SC . If you’re into microbiology, healthcare, or just curious about the tiny organisms that inhabit our planet, you’re in for a treat. This particular strain, SC2014SC , has garnered attention for various reasons, and we’re going to break it all down for you. We’ll explore what makes this bacterium tick, its significance in different contexts, and why understanding it is crucial. So, grab your lab coats (or just your comfy reading chairs) because we’re about to get microbiologically nerdy!
Table of Contents
Understanding Pseudomonas aeruginosa SC2014SC
Alright guys, let’s kick things off by understanding what Pseudomonas aeruginosa SC2014SC actually is. At its core, Pseudomonas aeruginosa is a Gram-negative, rod-shaped bacterium. It’s ubiquitous in nature, meaning you can find it pretty much everywhere – in soil, water, and even on surfaces. What makes it particularly interesting, and sometimes problematic, is its opportunistic nature . This means it usually doesn’t cause trouble for healthy individuals, but it can wreak havoc on those with weakened immune systems, like people with cystic fibrosis, burn victims, or those undergoing chemotherapy. The SC2014SC designation likely refers to a specific strain or isolate, perhaps identified through its genetic makeup or particular characteristics observed in a lab setting. Think of it like a specific breed of dog; while all dogs are dogs, a Golden Retriever has different traits than a Poodle. Similarly, Pseudomonas aeruginosa SC2014SC might have unique virulence factors, antibiotic resistance patterns, or metabolic capabilities that distinguish it from other Pseudomonas aeruginosa strains. Researchers often label specific isolates like this for tracking purposes and to study their unique behaviors. Its ability to thrive in diverse environments, including those with minimal nutrients and even in the presence of disinfectants, makes it a master survivor . This resilience is a key factor in its ability to cause infections, especially in healthcare settings where it can contaminate medical equipment and persist on surfaces. Furthermore, its genetic adaptability means it can quickly develop resistance to antibiotics, posing a significant challenge for treatment. This is why studying specific strains like SC2014SC is so important; it helps us understand the mechanisms behind its survival and resistance, leading to better strategies for control and treatment. The general characteristics of Pseudomonas aeruginosa include its motility (it can move!), its production of pigments (like pyocyanin, which gives it a blue-green color), and its ability to form biofilms. Biofilms are essentially communities of bacteria encased in a protective slime layer, making them much harder to eradicate. So, when we talk about Pseudomonas aeruginosa SC2014SC , we’re talking about a specific player in this complex microbial world, with its own set of superpowers and potential challenges.
The Significance in Healthcare
Now, let’s get real about why Pseudomonas aeruginosa SC2014SC and its kind are such a big deal in healthcare. These bacteria are notorious hospital-acquired infections (HAIs) , guys. Think about it: hospitals are environments where people are often vulnerable. If Pseudomonas aeruginosa gets a foothold, especially a strain like SC2014SC that might have specific resistance mechanisms, it can lead to serious complications. We’re talking about infections in the lungs (pneumonia), bloodstream infections (sepsis), urinary tract infections, and wound infections. For patients with underlying conditions, these infections can be life-threatening. Its ability to colonize moist environments makes it a common culprit in infections associated with ventilators, catheters, and surgical wounds. The antibiotic resistance is a massive headache here. Pseudomonas aeruginosa is intrinsically resistant to many common antibiotics, and strains like SC2014SC might possess additional resistance genes, making them difficult to treat with standard therapies. This often necessitates the use of more potent, sometimes more toxic, antibiotics, which can have their own side effects and contribute to the development of further resistance. The formation of biofilms is another crucial aspect in healthcare. These slimy communities can form on medical devices like implants, catheters, and ventilators, acting as a reservoir for infection. Eradicating bacteria within a biofilm is incredibly challenging because the slime layer protects them from antibiotics and the host’s immune system. Pseudomonas aeruginosa SC2014SC might be particularly adept at forming robust biofilms, further complicating patient care. Public health officials and researchers are constantly monitoring the prevalence and resistance patterns of Pseudomonas aeruginosa strains, including specific isolates like SC2014SC , to guide infection control strategies and antibiotic stewardship programs. Understanding the epidemiology of these infections – how they spread, who is most at risk, and what interventions are effective – is paramount. This involves meticulous surveillance, rapid diagnostics, and effective decontamination protocols in healthcare facilities to prevent transmission. The economic burden of HAIs caused by Pseudomonas aeruginosa is also substantial, encompassing extended hospital stays, increased treatment costs, and potential long-term disability or mortality. Therefore, the study of specific strains like SC2014SC is not just an academic exercise; it has direct implications for patient safety, public health, and the efficient allocation of healthcare resources. The challenge lies in staying one step ahead of this adaptable pathogen, developing new diagnostic tools, innovative treatments, and robust prevention strategies.
Virulence Factors and Mechanisms
So, how does Pseudomonas aeruginosa SC2014SC actually cause harm? It’s all about its virulence factors , which are essentially the weapons it uses to infect and damage its host. One of the most well-known is exotoxin A , a potent toxin that disrupts protein synthesis in host cells, leading to cell death. Pretty nasty stuff, right? Then there’s exoproducts , a general term for a cocktail of enzymes and toxins that bacteria secrete. This can include proteases, elastases, and lipases, which break down host tissues like skin, connective tissue, and cell membranes, making it easier for the bacteria to invade and spread. Pyocyanin , the pigment we mentioned earlier, also plays a role. It’s not just for show; it can generate reactive oxygen species, which damage host cells and contribute to inflammation. Quorum sensing is another fascinating mechanism. Bacteria use this chemical communication system to coordinate their behavior. Once a certain population density is reached, they